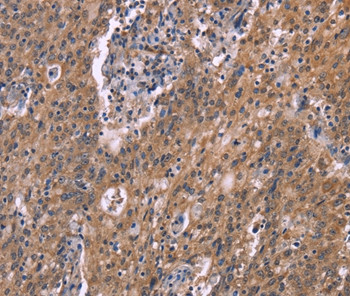
HSD11B2 Antibody in Immunohistochemistry (Paraffin) (IHC (P))

Search
Invitrogen
HSD11B2 Polyclonal Antibody
{{$productOrderCtrl.translations['antibody.pdp.commerceCard.promotion.promotions']}}
{{$productOrderCtrl.translations['antibody.pdp.commerceCard.promotion.viewpromo']}}
{{$productOrderCtrl.translations['antibody.pdp.commerceCard.promotion.promocode']}}: {{promo.promoCode}} {{promo.promoTitle}} {{promo.promoDescription}}. {{$productOrderCtrl.translations['antibody.pdp.commerceCard.promotion.learnmore']}}


Please note: We are reviewing Western blot images included in the antibody testing data in our catalog, including those provided by third parties. Unless expressly labeled or annotated as “raw-unedited”, Western blot images included in the antibody testing data in our catalog may have been edited, optimized or otherwise adjusted for presentation.
产品信息
PA5-50682
种属反应
宿主/亚型
分类
类型
抗原
偶联物
形式
浓度
规格
纯化类型
保存液
内含物
保存条件
运输条件
RRID
产品详细信息
The antibody detects endogenous levels of total HSD11B2 protein.
靶标信息
There are at least two isozymes of the corticosteroid 11-beta-dehydrogenase, a microsomal enzyme complex responsible for the interconversion of cortisol and cortisone. The type I isozyme has both 11-beta-dehydrogenase (cortisol to cortisone) and 11-oxoreductase (cortisone to cortisol) activities. The type II isozyme, encoded by this gene, has only 11-beta-dehydrogenase activity. In aldosterone-selective epithelial tissues such as the kidney, the type II isozyme catalyzes the glucocorticoid cortisol to the inactive metabolite cortisone, thus preventing illicit activation of the mineralocorticoid receptor. In tissues that do not express the mineralocorticoid receptor, such as the placenta and testis, it protects cells from the growth-inhibiting and/or pro-apoptotic effects of cortisol, particularly during embryonic development. Mutations in this gene cause the syndrome of apparent mineralocorticoid excess and hypertension.
仅用于科研。不用于诊断过程。未经明确授权不得转售。
篇参考文献 (0)
生物信息学
蛋白别名: 11-beta-hydroxysteroid dehydrogenase type 2; 11-beta-hydroxysteroid dehydrogenase type II; 11-DH2; 11-HSD type II; Corticosteroid 11-beta-dehydrogenase isozyme 2; NAD-dependent 11-beta-hydroxysteroid dehydrogenase; Short chain dehydrogenase/reductase family 9C member 3
基因别名: HSD11B2; HSD11K; SDR9C3
Entrez Gene ID: (Human) 3291